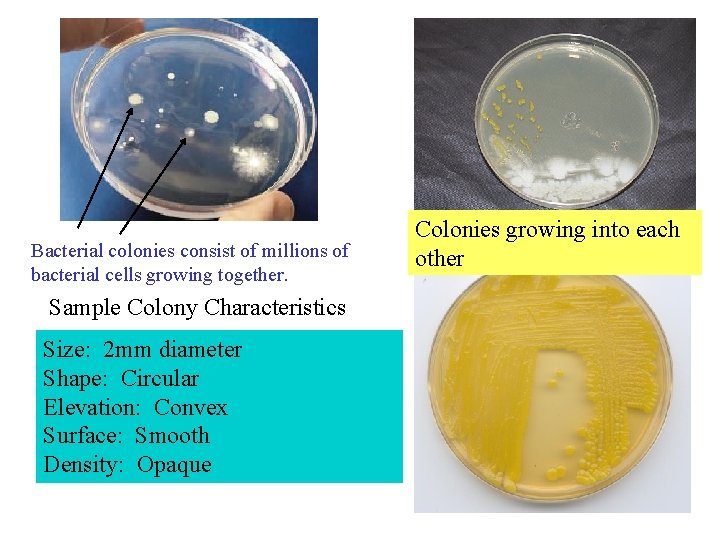
Bacterial colonies consist of millions of bacterial cells growing together. Sample Colony Characteristics Size:
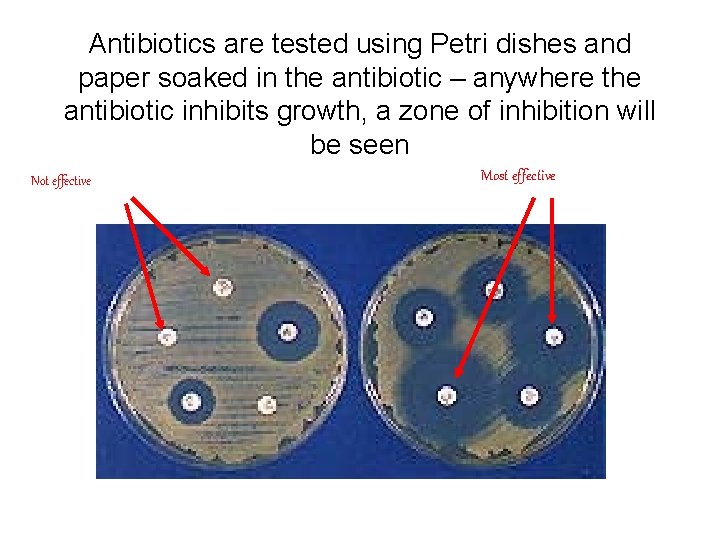
Antibiotics are tested using Petri dishes and paper soaked in the antibiotic – anywhere

Bacteria 2 Domains Archaebacteria and Eubacteria The closest

Bacteria – 2 Domains (Archaebacteria and Eubacteria) • The closest estimate is that there are 5 million trillion bacteria on Earth – that’s a 5 with 30 zeroes after it. • Bacteria produce the air we breathe, clean the water we drink, and create fertile soil. • Less than one percent of bacteria cause diseases.

Bacteria structure – prokaryotic notice no nucleus plasmid

Bacterial Reproduction Binary Fission – some bacteria can divide as often as every 20 minutes! Binary fission is an asexual reproduction process. All offspring should be genetically identical to the parent cell and to each other.

Binary Fission

Methods of DNA Exchange Even though bacteria reproduce asexually, they show methods of exchanging DNA pieces that increases their variability. There are 3 main methods: a) Conjugation b) Transduction c) Transformation

Methods of Exchanging DNA Conjugation – two bacteria join by a cytoplasmic bridge and exchange small circles of DNA called plasmids. The cells may in this way exchange useful information.

Conjugation animation

Methods of Exchanging DNA Transduction - the process by which DNA is transferred from one bacterial cell to another by infection with a virus. Viruses that infect bacteria are called bacteriophages. Bacteriophage

Transduction Bacterial transduction animation

Methods of Exchanging DNA Transformation- a living bacterial cell takes in the DNA from a dead bacterial cell. The DNA is then incorporated into the genome of the living cell.

Transformation Bacterial transformation animation

DOMAIN Archaebacteria Are EXTREMOPHILES (love extreme environments) § Are usually found in harsh environments – hot, salty, acidic. Are ANCIENT– probably resemble the first bacteria and therefore the first life forms on the planet § Exobiologists (biologists who are looking for life on other planets or moons) guess that they should be looking for these types of cells. WHY?

Archaebacteria : Methanogens (generate methane) • produce methane – live in digestive tract of mammals, in swamps and sewage)

Archaebacteria: Thermophiles • can live in extremely hot water – found in hot springs

Halophiles • Live in very salty (halides) environments, such as the Great Salt Lake in Utah and the Dead Sea

Domain Eubacteria – true bacteria • Many types – modern bacteria • Classification is by: – Cell shape – Nutrition – Respiration

Cell Shape Coccus - round Bacillus - rod Spirillum - spiral

Some bacteria grow alone, but others form colonies • Diplo…means two – Diplococcus – Diplobacillus • Strepto… means chain - as in streptococcus - and streptobacillus • Staphylo… means cluster • As in staphlyococcus or
Bacterial colonies consist of millions of bacterial cells growing together. Sample Colony Characteristics Size: 2 mm diameter Shape: Circular Elevation: Convex Surface: Smooth Density: Opaque Colonies growing into each other

Nutrition – Autotrophic or Heterotrophic Autotrophs – make their own food – use sun’s energy or chemical energy – E. g. cyanobacteria (blue-green algae, nitrogenfixing bacteria)

Most Bacteria are Heterotrophs Escherichia coli Spirillum Found in intestines Anthrax Deadly respiratory bacteria Can cause certain STD’s

3 Types of Heterotrophic Bacteria 1. Saprophytic - Those bacteria who live and get nutrients by digesting dead plants/animals or their wastes. These bacteria are decomposing bacteria. Saprophytic colony on tree trunk

3 Types of Heterotrophic Bacteria 2. Parasitic – obtain food by living attached to or inside living organisms. These are harmful to the host organism, as they feed directly on the tissues of the organism. These may cause disease (in which case, they are called pathogens).

Types of Heterotropic Bacteria Parasitic bacteria Staphylococcus aureus – causes pimples, boils, pneumonia, sepsis Streptococcus mutans – causes tooth decay

3. Types of Heterotrophic Bacteria 3. Mutualistic or Symbiotic bacteria – these bacteria feed off of other living organisms but have no harmful effect on the host organism.

Types of Heterotrophic Bacteria Mutualistic or Symbiotic Bacteria E. Coli – intestinal bacteria Nitrogen fixing bacteria – plant roots

Respiration – process of getting energy from food Aerobic bacteria These bacteria need oxygen to metabolize (break down) food. If a bacterium cannot live without oxygen, it is known as an obligate aerobe. example – tuberculosis (TB) bacterium Tb lung If a bacterium prefers to live with oxygen it is known as a facultative aerobe.

Anaerobic bacteria These bacteria do not need oxygen. In some cases, these bacteria cannot survive in the presence of oxygen, in which case they are called obligate anaerobes. example: tetanus This baby probably got tetanus from honey – don’t give honey to a baby!

Some bacteria can live in the presence of oxygen, but do not require it for survival. These are known as facultative anaerobes. Example: E. coli

How important are bacteria to the world? • • Decomposition Food web Nitrogen cycle Digestion Food production Bioremediation Production of antibiotics

Food web

Nitrogen cycle Bacteria recycling and incorporating nitrogen (N), for protein manufacturing.

Cow Digestion Bacteria in the stomach - Help breakdown plant products for herbivores.

Foods from bacteria cheese yogurt sauerkraut

• Bioremediation – using microorganisms to rid environment of harmful substances – Ex – oil spill site – Hazardous waste site – Sewage treatment
Antibiotics are tested using Petri dishes and paper soaked in the antibiotic – anywhere the antibiotic inhibits growth, a zone of inhibition will be seen Not effective Most effective

Antibiotic Resistance Antibiotics are chemicals that are selectively toxic (they are toxic to certain cells, and not others). They kill or inhibit the growth or reproduction of bacterial cells. Some prevent bacterial cells from producing parts they need, other actually break the bacterial cell wall.

Antibiotic Resistance Some bacteria have evolved defenses against antibiotics. They may inactivate the antibiotic or a mutation may have changed the bacterial compound that would normally be affected by the drug. Because bacteria are able to exchange DNA (conjugation, transduction, transformation), it is easy for the resistance to be passed on to other bacteria. Antibiotic resistance animation

• Read section 2. 2 pages 59 - 66 and answer questions #1, 2, 3, 5, and 7
- Slides: 39